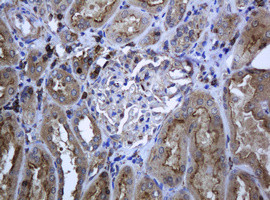
RAB21 Antibody in Immunohistochemistry (Paraffin) (IHC (P))

Search
OriGene
RAB21 Monoclonal Antibody (OTI6B1), TrueMAB™
{{$productOrderCtrl.translations['antibody.pdp.commerceCard.promotion.promotions']}}
{{$productOrderCtrl.translations['antibody.pdp.commerceCard.promotion.viewpromo']}}
{{$productOrderCtrl.translations['antibody.pdp.commerceCard.promotion.promocode']}}: {{promo.promoCode}} {{promo.promoTitle}} {{promo.promoDescription}}. {{$productOrderCtrl.translations['antibody.pdp.commerceCard.promotion.learnmore']}}
产品信息
TA505776
种属反应
宿主/亚型
分类
类型
克隆号
抗原
偶联物
形式
浓度
纯化类型
保存液
内含物
保存条件
运输条件
靶标信息
RAB21 is a member of a subfamily of small GTP-binding protein genes of the Ras superfamily that plays an important role in intracellular vesicular targeting. In non-polarized Caco-2 cells, RAB21 showed a general endoplasmic reticulum (ER)-like localization, while in polarized cells, RAB21 localized to apical vesicles. RAB21 has been shown to associate with integrin subunits and to be important for receptor entry into cells via RAB5/RAB21 endosomes. The GTPase-activating protein p120RasGAP regulates cell motility by controlling the return of the endocytosed integrins to the plasma membrane by competing with RAB21 for binding to overlapping sites on the Alpha-tail of endocytosed integrin.
仅用于科研。不用于诊断过程。未经明确授权不得转售。
篇参考文献 (0)
生物信息学
蛋白别名: GTP-binding protein RAB21; Ras-related protein Rab-21
基因别名: KIAA0118; RAB21
UniProt ID: (Human) Q9UL25
Entrez Gene ID: (Human) 23011